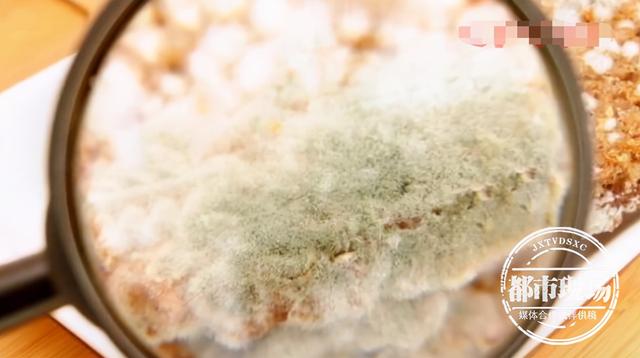
一个多月咳喘不止,女子肺部长满真菌!只因接触了霉变玉米休闲区蓝鸢梦想 - Www.slyday.coM 一个多月咳喘不止,女子肺部长满真菌!只因接触了霉变玉米休闲区蓝鸢梦想 - Www.slyday.coM

来源丨都市现场综合湖北经视
在湖北武汉务工的小刘今年23岁,她已经连续一个多月咳喘不止,在家吃药也不见好转,于是小刘赶到医院,检查提示她肺部有感染。但医生却发现小刘的病情,与一般肺炎感染有所不同。

为了确定感染的具体原因,医生紧急为小刘进行肺泡灌洗后,发现她的肺部竟然长满黄曲霉菌,引发了真菌感染,这真菌怎么会长到肺里面呢? 经过详细询问病史,医生得知一个多月前,小刘曾回老家帮家人收玉米,医生分析,她发病原因于此有关。
武汉市第四医院呼吸与危重症医学科住院医师郭蒲剑:患者收的玉米可能已经被大量黄曲霉菌污染。在收玉米过程中,大量黄曲霉菌孢子扩散到空气中,而小刘没有采取任何防护措施,短时间内将大量黄曲霉菌吸入气道,在肺部定植,最终导致严重肺部感染。

医生介绍,黄曲霉菌是一种大自然常见的霉菌,尤其是花生、玉米易污染黄曲霉及其毒素。黄曲霉菌会造成肺的曲菌症,有时候也会引起角膜、耳与鼻眼眶的感染。黄曲霉的孢子也是一种过敏原,易引起过敏反应。此外,食用被黄曲霉菌污染的食物,可能摄入黄曲霉毒素,具有很强的致癌性。

对此,医生建议市民在日常生活中,千万不要吃霉变的食物,尤其是发霉的花生、干果等。

武汉市第四医院呼吸与危重症医学科住院医师郭蒲剑:晾晒、收纳玉米、花生的农作物时,要注意环境的通风,尽量站在上风口进行操作;同时做好个人防护,戴密闭性较好的口罩;如果本身如果有气道过敏性疾病的,应尽量避免接触。
